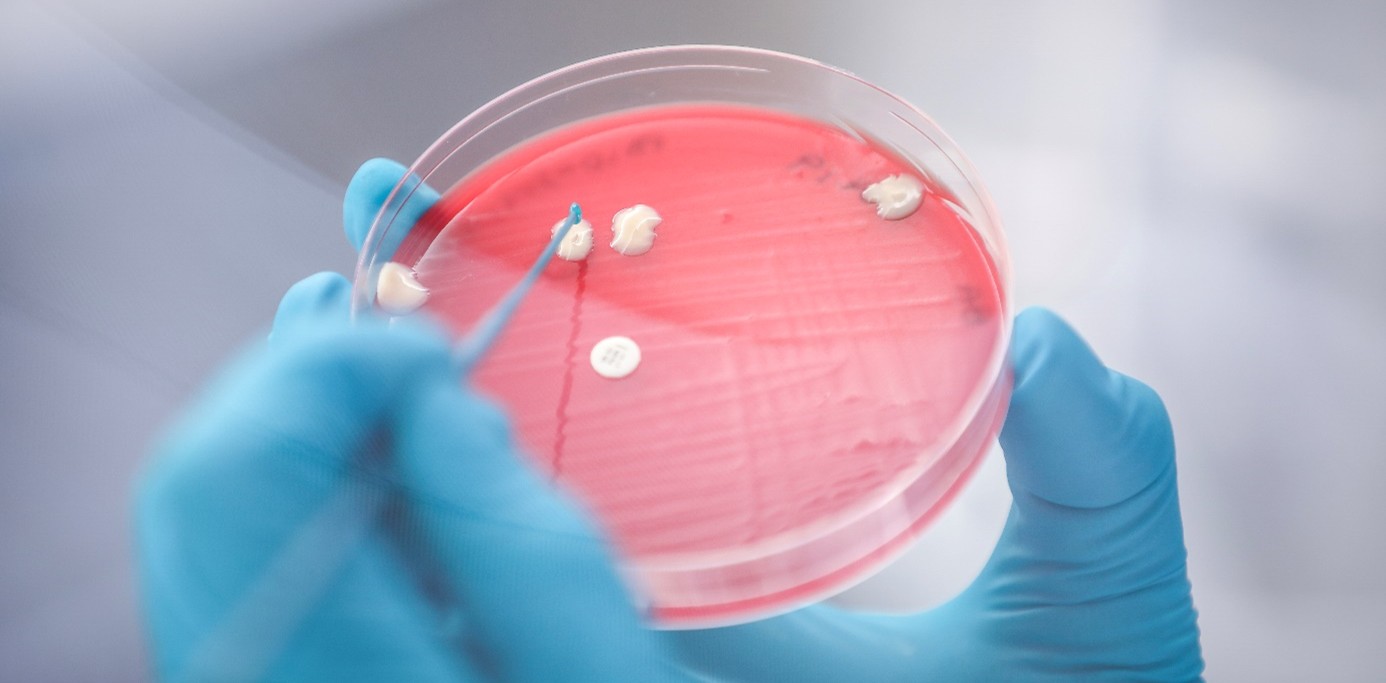

Vintersår er en alvorlig infeksjonssykdom som fører til at fisken lider og dør, og slaktekvaliteten reduseres. Sårene skjuler ofte kompliserte årsakskjeder og bør undersøkes med helhetlige metoder, råder fiskehelseekspertene i Pharmaq.
Vintersår er en av de mest alvorlige utfordringene innen norsk oppdrett. Langs hele norskekysten infiserer bakterier oppdrettslaks og lager sår. Infeksjonene opptrer oftest om vinteren, ettersom bakteriene som lager sårene trives best i kaldt vann.
Hege Hellberg, veterinærpatolog i Pharmaq Analytiq, er ikke i tvil om hva som er den beste metoden for å undersøke vintersår.
– Vintersår kommer ofte som følge av flere faktorer, og flere bakterier påvises gjerne i samme utbrudd. Det er viktig å få mest mulig informasjon om bakteriene og hvorfor sårene dukker opp for å behandle utbruddene best mulig. Derfor bør du gjøre helhetlige undersøkelser med mikrobiologi, gjerne i kombinasjon med histologi og PCR, sier Hellberg i en pressemelding.
Mikrobiologi gir flere svar
Helhetlige undersøkelser med mikrobiologi starter med et godt prøveuttak. Hellberg, som har doktorgrad i fiskeanatomi og flere tiårs erfaring med diagnostikk av fisk, anbefaler å ta prøver fra både selve såret og fiskens indre organer.
I laboratoriet følger mikrobiologene følge med på hvordan de levende bakteriene utvikler seg. Det kan gi verdifull informasjon om for eksempel bakteriens egenskaper, resistens eller samspill med andre smittestoffer.
Til sammenlikning er PCR en rask og spesifikk undersøkelsesmetode som kun gir ja/nei-svar på om bestemte smittestoffer finnes i en prøve.
– PCR kan fint brukes i kombinasjon med andre undersøkelser av såret, men vi anbefaler ikke å bruke PCR alene, sier Hellberg.
Miljøet rundt påvirker sårutviklingen
Vintersår involverer ofte bakterier som Moritella viscosa, Tenacibaculum og Aliivibrio wodanis. Samtidig spiller miljøet rundt fisken en betydelig rolle for hvordan sårene utvikler seg.
– Fisken blir eksponert for disse bakteriene gjennom naturlig tilstedeværelse i sjøvann. Bakteriene blir imidlertid holdt i sjakk av fiskens immunrespons og det beskyttende slimlaget som er en del av hudbarrieren, sier Hellberg.
Kaldt vann gjør Moritella viscosa mer sykdomsfremkallende og reduserer fiskens immunrespons. Annen sykdom eller mekanisk avlusing kan også svekke fisken, slik at bakterien klarer å danne sår, forklarer Hellberg.
De kompliserte årsakssammenhengene gjør helhetlige undersøkelser ekstra viktig.

PCR kan slå ut på feil bakterie
Noen ganger viser det seg at vintersårbakteriene ikke er til stede i fisken i det hele tatt. Da kan andre bakterier, virus eller helt andre forhold være problemet, forklarer Hellberg.
Men selv når PCR påviser vintersårbakterier, er ikke det nødvendigvis det endelige svaret. Moritella viscosa kan for eksempel gi svakt positivt utslag i helt normal laksehud, uten at bakterien faktisk forårsaker sykdom.
I tillegg er flere av bakteriene som finnes i vintersår nært beslektet og utveksler genetisk materiale. Det kan gi kryssreaksjoner som gjør at PCR-testen slår ut på feil bakterie.
– Alt dette illustrerer at vintersår må undersøkes grundig. PCR alene gir ikke nok informasjon, sier Hellberg.
Levende prøvemateriale gir mer informasjon
La oss ta et eksempel: I dag kjenner vi til tre varianter av Moritella viscosa – klassisk, variant og klassisk ikke-viskøs. For å sikre at vaksinene gir god dekning, må man avdekke hvilken variant som forårsaker sårene og om det skjer endringer over tid.
Hvis det dukker opp nye varianter, er det ikke sikkert PCR kan skille mellom variantene. Bakteriene kan ha forskjeller som kun kan sees ved å dyrke bakteriene i laboratoriet.
Det gir gode muligheter for å beskrive og identifisere ulike varianter og undertyper av bakteriene.
– Den mikrobiologiske undersøkelsen kan også suppleres med PCR for å raskt verifisere spesifikke egenskaper, eller en histologisk analyse for å undersøke vevsprøver nøye, forteller Hellberg.
Dyrest å ta prøver om igjen
Mikrobiologisk undersøkelse koster litt mer og tar noen flere dager å gjennomføre enn PCR. Men ekspertene i Pharmaq Analytiq er ikke i tvil om at det lønner seg for oppdretterne i lengden.
– Det dyreste er å måtte reise ut på nytt og ta nye prøver. Når du først er der ute og skal utrede et sykdomsproblem, gjør et fullt prøveuttak som inkluderer mikrobiologisk undersøkelse. Da slipper du å styre med å sende inn prøver på nytt, sier Hellberg.
Fakta: Vintersår
- En bakteriell sårinfeksjon som rangeres som en av de største velferdsutfordringene for oppdrettsnæringen i sjøfasen.
- Den klassiske formen for vintersår knyttes til bakterien Moritella viscosa. Bakterien angriper huden, og kan i tillegg infisere indre organer som hodenyre, milt, lever og blodbane – da kalles det en systemisk infeksjon.
- I tillegg er bakteriene Tenacibaculum og Aliivibrio wodanisogså assosiert med sårutvikling. Tenacibaculum kan gi infeksjonen tenacibaculose – en infeksjon som gir overflatiske sår og råte på fiskens kjeve, hode og finner.
- Bakteriene opptrer både alene og sammen.
- Forekommer oftest høst/vinter, ettersom bakteriene trives best i kaldt sjøvann.
- 289 lokaliteter fikk påvist klassisk vintersår med bakterien Moritella viscosa i 2024. Samme år fikk 159 lokaliteter påvist vintersår med Tenacibaculum spp. Tilfellene forekommer langs hele norskekysten.
- Moritella viscosa kan gi systemisk infeksjon, altså at sykdommen sprer seg til indre organer. Tenacibaculum gir nesten utelukkende hudinfeksjon, ofte med sår rundt hode/munn.
Det meste av norsk laks vaksineres mot Moritella viscosa. Det finnes ingen kommersiell vaksine mot Tenacibaculum.






